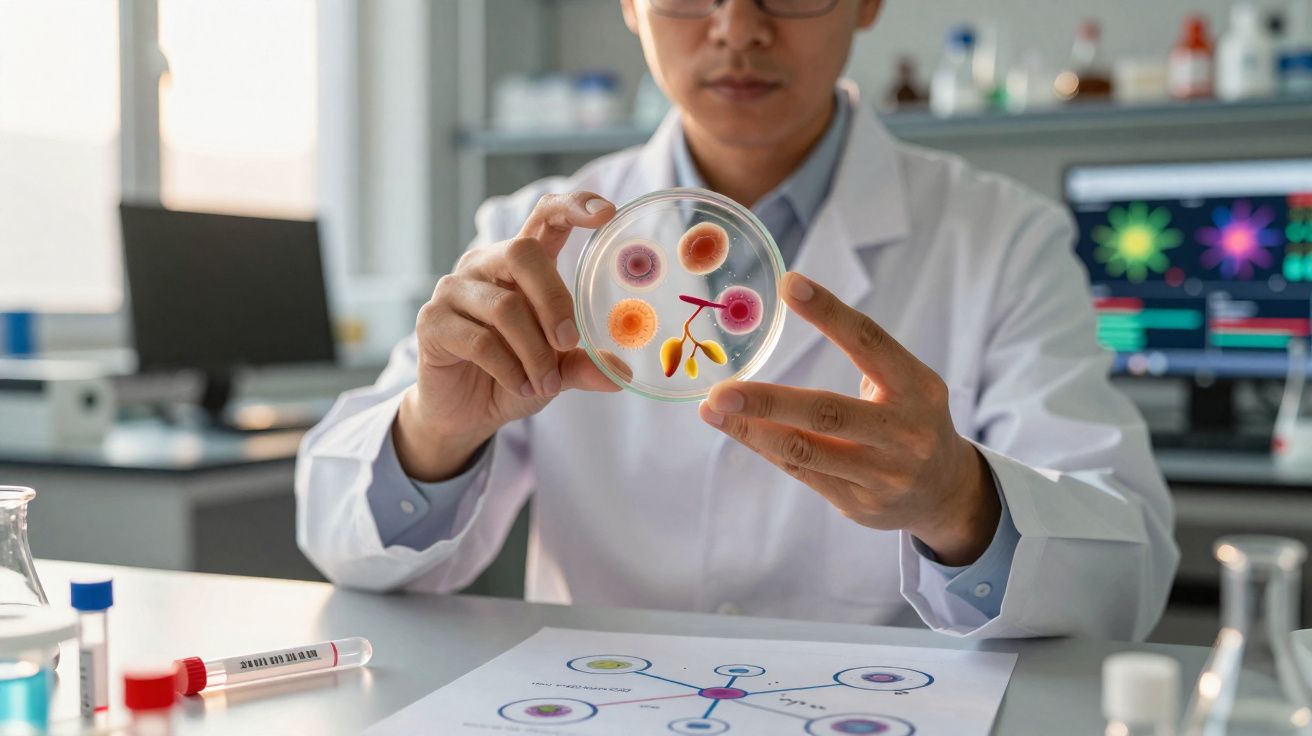
Cientista em laboratório a observar placa de Petri com colónias de microrganismos coloridos.

Apesar dos progressos acelerados da inteligência artificial nos últimos anos, o cérebro humano continua a superar os computadores numa capacidade crucial: aprender em diferentes contextos e transportar competências de uma tarefa para outra. Um novo estudo ajuda a esclarecer como é que isso poderá acontecer ao nível neuronal.
O que a Universidade de Princeton investigou (sem testar humanos)
A equipa responsável, liderada por investigadores da Universidade de Princeton, não realizou experiências diretamente com pessoas. Em vez disso, recorreu a animais muito próximos de nós em termos de biologia e funcionamento cerebral: macacos-rhesus (Macaca mulatta).
Os animais participaram em tarefas realizadas num ecrã, nas quais tinham de distinguir formas e cores. Para assinalarem a resposta, eram treinados a olhar para direções específicas, associadas a cada opção.
Três tarefas relacionadas e aprendizagem contínua
Como é possível observar no vídeo referido pelos autores, os macacos tiveram de alternar entre três tarefas distintas, mas interligadas, exigindo que aprendessem continuamente e, sobretudo, que aplicassem aquilo que já tinham adquirido numa tarefa anterior para resolver a seguinte.
Enquanto isso acontecia, os investigadores acompanharam a atividade cerebral com exames que permitiram procurar padrões sobrepostos e zonas de atividade partilhadas entre tarefas.
Legos cognitivos no córtex pré-frontal do cérebro humano (e dos macacos)
As imagens revelaram que o cérebro dos macacos não usa sempre o mesmo “caminho” para tudo. Pelo contrário, recorre a diferentes conjuntos de neurónios, descritos pelos investigadores como “Legos cognitivos”, que podem ser reaproveitados e recombinados conforme a necessidade.
Esses Legos cognitivos surgiram concentrados no córtex pré-frontal, uma região associada à cognição de nível superior - resolver problemas, planear e tomar decisões - e que parece ter um papel central na flexibilidade cognitiva.
Reutilização de blocos mentais: porque a IA ainda fica para trás
Segundo os autores, esta organização em blocos explica uma vantagem importante do cérebro: a capacidade de montar novas soluções a partir de componentes já existentes, algo que os melhores modelos de IA ainda não conseguem igualar com a mesma consistência.
O neurocientista Tim Buschman, da Universidade de Princeton, sublinha que os modelos mais avançados de IA podem atingir desempenho humano - ou até acima do humano - numa tarefa isolada, mas tendem a ter dificuldades quando precisam de aprender e executar muitas tarefas diferentes.
A ideia central é simples: se o cérebro consegue reutilizar componentes da cognição em múltiplos desafios, então, ao “encaixar” esses Legos cognitivos, consegue construir rapidamente novas tarefas sem começar do zero.
Quando um bloco não é preciso, o cérebro reduz o “ruído”
O estudo também identificou um pormenor relevante: quando determinados blocos cognitivos não eram necessários, a atividade nesses circuitos diminuía. Isto sugere que o cérebro consegue, por assim dizer, “arrumar” temporariamente os Legos neuronais que não fazem falta naquele momento, melhorando o foco na tarefa em curso.
Buschman compara um bloco cognitivo a uma função num programa de computador: um conjunto de neurónios pode tratar, por exemplo, da discriminação de cor, e o resultado pode ser encaminhado para outro “módulo” que desencadeia a ação (como olhar para uma direção específica). Essa sequência de componentes permite executar uma tarefa passo a passo, com partes reutilizáveis.
O problema do esquecimento catastrófico na inteligência artificial
Esta flexibilidade ajuda a explicar como macacos - e possivelmente humanos - conseguem adaptar-se a desafios que nunca viram, aplicando conhecimento anterior para lidar com o novo. Já a inteligência artificial, na sua forma atual, luta com um problema conhecido como esquecimento catastrófico: muitas redes neuronais têm dificuldade em aprender tarefas consecutivas sem perder desempenho na tarefa anterior.
Embora alternar constantemente entre tarefas não seja propriamente “ideal” para o nosso cérebro, transferir competências de uma atividade para outra pode funcionar como um atalho eficiente, poupando tempo de aprendizagem.
O que isto pode mudar no treino de IA e na saúde mental
A médio e longo prazo, os investigadores consideram que estas conclusões podem inspirar formas de treinar sistemas de IA mais adaptáveis a tarefas novas, aproximando-os da capacidade humana de recombinação de conhecimentos.
Os resultados também podem ser úteis no desenvolvimento de abordagens para perturbações neurológicas e psiquiátricas em que as pessoas têm dificuldade em aplicar competências a contextos diferentes, mesmo quando as dominam num ambiente específico.
Um ponto adicional: implicações para aprendizagem humana e reabilitação
Se o cérebro realmente trabalha com componentes reutilizáveis, isto reforça a importância de treinos que promovam generalização - por exemplo, praticar uma competência em vários cenários (com mudanças de estímulo, regras e objetivos) para incentivar a transferência. Em reabilitação cognitiva, pode também abrir espaço a estratégias que identifiquem quais os “blocos” preservados e quais os que precisam de ser reforçados, em vez de tentar reensinar tudo como um conjunto único e rígido.
Outra nota relevante: limites e cautelas na interpretação
Apesar de os macacos-rhesus serem um modelo muito próximo, é prudente evitar uma equivalência direta e total com o cérebro humano. A força do estudo está em apontar um mecanismo plausível de flexibilidade - a recombinação de blocos no córtex pré-frontal -, mas a tradução completa destes resultados para humanos exigirá investigação complementar, incluindo abordagens que avaliem como estes blocos se manifestam em tarefas do quotidiano.
Conclusão
Os autores concluem que, se o cérebro consegue reutilizar representações e cálculos entre tarefas, então pode adaptar-se rapidamente às mudanças do ambiente - quer aprendendo a representação correta da tarefa através de feedback de recompensa, quer recuperando-a da memória de longo prazo.
A investigação foi publicada na revista científica Nature.

Comentários
Ainda não há comentários. Seja o primeiro!
Deixar um comentário